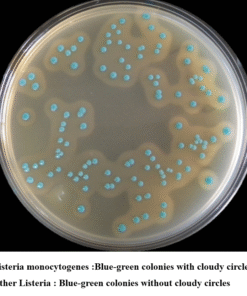
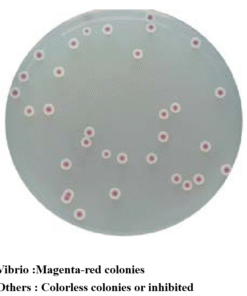

Продукция, которой доверяют лидеры рынка
Ассортимент HuanKai включает более 2000 наименований. Мы гордимся тем, что представляем продукцию, которой доверяют такие мировые лидеры, как PepsiCo, Danone, The Coca-Cola Company, Amway, Bayer AG и многие другие.
Наши решения
Мы предлагаем комплексные решения для лабораторных исследований, охватывающие ключевые направления:
Классическое микробиологическое тестирование: Реагенты и расходные материалы, включая культуральные среды от ведущего бренда HKM.
Экспресс-тесты: Современные решения от бренда BHK (HuanKai Biology) для быстрой идентификации микроорганизмов, производства вакцин и генной инженерии.
Оборудование и расходные материалы: Лабораторные приборы, а также расходники для микробиологических исследований, включая решения для анализа воды и реагенты от бренда CHK.
Моющие и дезинфицирующие средства: Эффективные и экологически безопасные продукты для лабораторий и производственных линий, также разработанные под брендом
Мы гордимся тем, что предоставляем продукцию, которая отвечает самым высоким требованиям качества и надежности.
| Код | Название продукта | Объем | Предполагаемое применение |
| CRM001 | Хромогенный агар для колиформ | 1000 мл | Для быстрого обнаружения колиформ. |
| CRM002 | Хромогенный агар для E. coli | 1000 мл | Для быстрого обнаружения E. coli. |
| CRM003 | Хромогенный агар для колиформ и E. coli | 1000 мл | Для быстрого обнаружения колиформ и E. coli. |
| CRM004 | Хромогенный агар для сальмонелл | 1000 мл | Для обнаружения и выделения Salmonella spp. |
| CRM005 | Хромогенный агар для бацилл (с добавкой) | 1000 мл | Для обнаружения и дифференциации группы Bacillus cereus. |
| CRM006 | Хромогенный агар для Enterobacter sakazakii | 1000 мл | Для обнаружения E. sakazakii. |
| CRM007 | Хромогенный агар для E. coli O157 (с добавкой) | 1000 мл | Для селективного выделения и дифференциации E. coli O157. |
| CRM008 | Хромогенный агар для вибрионов | 1000 мл | Для выделения и обнаружения вибрионов, особенно Vibrio parahaemolyticus. |
| CRM009 | Хромогенный агар для Vibrio cholerae | 1000 мл | Для выделения и обнаружения Vibrio cholerae. |
| CRM010 | Хромогенный агар для Candida | 1000 мл | Для выделения и дифференциации Candida. |
| CRM011 | Хромогенный агар для шигелл | 1000 мл | Для выделения и дифференциации Shigella. |
| CRM012 | Хромогенный агар для Staphylococcus aureus | 1000 мл | Для выделения и дифференциации Staphylococcus aureus. |
| CRM013 | Хромогенный агар для Listeria monocytogenes (с добавкой) | 1000 мл | Для выделения и дифференциации Listeria monocytogenes. |
| CRM014 | Хромогенный агар для листерий (с добавкой) | 1000 мл | Для выделения и дифференциации Listeria. |